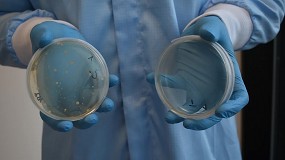
Foto de BI-OME, tecnolog�a antimicrobiana para prendas interiores de sala blanca.

Alsico Iberia, S.L. - Noticias
Nuestra razón de ser es que cada profesional trabaje con la confianza de sentirse bien: una conversación con Eduard Bacardit, director general de Alsico Iberia
En la antesala de SICUR, nos sentamos con el responsable de Alsico Iberia. Lejos de hablar de cifras o catálogos, su discurso se centra en un concepto que la marca ha convertido en su bandera: la protección del rendimiento humano a través de la excelencia en el diseño.[+]
Lo que no se ve cuando una prenda funciona: la estructura que permite cuidar del rendimiento humano
Cuando el vestuario funciona, pasa desapercibido. No genera incidencias, no provoca rechazo por parte de quien lo lleva y no obliga a intervenir continuamente para corregir desviaciones. En entornos industriales exigentes, esa normalidad es el resultado de una estructura que ha sido pensada para acompañar el trabajo de las personas, no solo para cumplir una ficha técnica. [+]Donde el discurso se convierte en algo que se puede tocar
En industria, las palabras sirven de poco si no se traducen en cosas que funcionan. Hablar de cuidar del rendimiento de las personas, de no interferir en su forma de trabajar o de pensar en la durabilidad como algo que se vive en el día a día, solo cobra sentido cuando esas ideas se vuelven físicas: en un tejido que responde cuando el cuerpo se mueve, en una prenda que no se convierte en un obstáculo con el paso de las horas, en una protección que sigue siendo protección después de semanas de uso y lavados exigentes... [+]Kibo, la nueva revolución en vestuario multirriesgo de Alsico
Alsico presentará Kibo en la feria A+A 2025 (Hall 15, Stand A48), marcando un antes y un después en la protección laboral con un tejido que combina seguridad, comodidad, flexibilidad y sostenibilidad. Durante décadas, las prendas de protección multirriesgo se han asociado con peso, rigidez y falta de confort. Alsico rompe con ese paradigma con Kibo, su nueva línea de vestuario técnico desarrollada con tecnología Alsipro, un avance textil que ofrece protección de alto rendimiento sin sacrificar la libertad de movimiento... [+]Limpieza y mantenimiento de los EPI
La normativa legal es clara (*): el fabricante está obligado a proporcionar información sobre las condiciones de limpieza y mantenimiento de los equipos de protección individual (EPI), y la empresa que los adquiere tiene la responsabilidad de aplicar estas indicaciones para garantizar la seguridad del usuario. Aunque este es un tema conocido tanto por fabricantes como por empresarios, a menudo queda relegado a un segundo plano, generando una brecha entre la información que proporciona el fabricante y el conocimiento práctico del usuario final... [+]La alianza entre Alsico y Sixone redefine la circularidad en la industria de la ropa laboral
El grupo Alsico, especialista mundial en vestuario laboral y de protección de alto rendimiento, y Sixone, empresa que transforma los textiles mezclados con poliéster posconsumo procedentes de vertederos en pellets de poliéster de alta calidad, han iniciado una alianza estratégica. Esta unión marca un hito importante en el compromiso de Alsico con la sostenibilidad y la innovación, ya que, como primer fabricante a gran escala de Europa en asociarse con Sixone, la empresa está lista para marcar un antes y un después en la economía circular de la industria de la ropa de trabajo... [+]Alsico publica su informe ESG anual y reafirma su compromiso con la sostenibilidad
El grupo Alsico presenta su Informe ESG 2024, reafirmando su compromiso con un futuro más sostenible, inclusivo y ético. Bajo el lema The Better Future System, la empresa da un paso firme hacia una transformación responsable en la industria del vestuario profesional.[+]
Alsico presenta su tecnología Alsiflex en el I Congreso del EPI de Asepal
Alsico, uno de los principales fabricantes globales de vestuario laboral, técnico y de protección a gran escala de la Península Ibérica, es uno de los Patrocinadores Plata del I Congreso del EPI de Asepal, que se llevará a cabo los próximos días 21 y 22 de mayo en el Business Center Laureana de San Sebastián de los Reyes (Madrid). Su tecnología textil Alsiflex, que integra sostenibilidad, comodidad y protección en el vestuario laboral, es la protagonista del póster científico que la empresa presentará en esta primera edición del Congreso... [+]Vestilab y Contec organizan una ponencia sobre residuos de desinfectantes en salas blancas
¿Afectan los residuos a una sala blanca? El próximo 19 de febrero, Vestilab organiza junto con Contec la ponencia Cleanroom Disinfectant Residues Management and Mitigation, donde abordarán formas eficaces de eliminar los residuos de desinfectantes en salas blancas. En esta sesión, Neil Simpson and Karen Rossington hablarán de los desinfectantes más utilizados en salas blancas, los residuos que dejan y sugerirán algunos enfoques prácticos para abordar este problema... [+]BI-OME, tecnología antimicrobiana para prendas interiores de sala blanca.
Alsico presenta BI-OME, la tecnología revolucionaria que garantiza una frescura e higiene óptimas para los textiles de sala blanca. BI-OME limpia con éxito las prendas de microorganismos y reduce la actividad de los virus. Como no se utilizan sustancias tóxicas ni peligrosas, ni las personas ni el medio ambiente se ven afectados. Y mientras que los antimicrobianos tradicionales pierden gradualmente su eficacia con el tiempo, BI-OME permanece activo durante todo el ciclo de vida de los productos tratados... [+]Alsico celebra un seminario dedicado al vestuario para Salas Blancas y entornos controlados
El miércoles 16 de octubre de 2024, Alsico organizó en colaboración con Vestilab el seminario Control de Contaminación en Salas Blancas - 1 año de experiencias reales bajo el GMP Anexo 1. El compromiso con la mejora continua y la protección del ambiente en zonas controladas les llevó a reunir a expertos del sector farmacéutico para compartir experiencias reales.[+]
Alsico presenta en Barcelona prendas innovadoras para la industria de electrificación
En un contexto donde las soluciones de almacenamiento de energía son clave para un futuro más sostenible, Alsico ha dado un paso al frente presentando su nueva colección de vestuario especializado en el evento Excellence in Battery Manufacturing Processes and Technology, celebrado en Barcelona.[+]
Alsiflex: la tecnología que combina sostenibilidad, comodidad y protección
Alsico, empresa especializada en vestuario laboral técnico y de protección, trabaja diariamente para cambiar la vida de las personas en el trabajo, innovando y aplicando su experiencia de más de 80 años en el sector para lograr prendas que permiten a los usuarios desempeñar sus funciones al máximo de sus capacidades.[+]